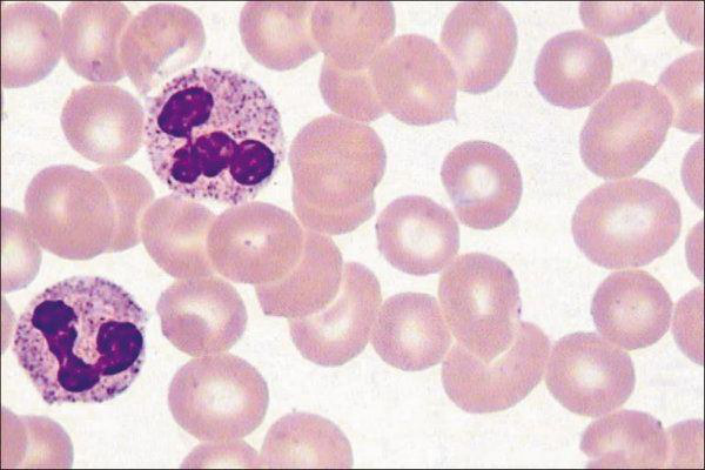

4.3.2 中性粒细胞
-
1 内容
-
2 测验
上一节
下一节
形态
● 呈球形,直径10-12μm。
● 核深染,呈弯曲杆状或分叶状,一般为2-5叶。
● 胞质染成粉红色,含有细小的淡紫色及淡红色颗粒。
血细胞仿真图:

中性粒细胞光镜像(Wright-Giemsa,10×40):
中性粒细胞透射电镜像:

核左移
杆状核与1-2叶核的细胞增多,见于严重细菌感染。
核右移
4-5叶核的细胞增多,见于骨髓造血功能障碍。
功能
1.嗜天青颗粒(溶酶体),含酸性磷酸酶、髓过氧化物酶、多种酸性水解酶类等;特殊颗粒(分泌颗粒),含溶菌酶、吞噬素等。
2.中性粒细胞在体内起着重要的防御作用。当机体受细菌感染时,中性粒细胞增多。
3.中性粒细胞吞噬细菌后,自身也死亡,成为脓细胞。
中性粒细胞吞噬细菌示意图:

中性粒细胞吞噬细菌示意图:


